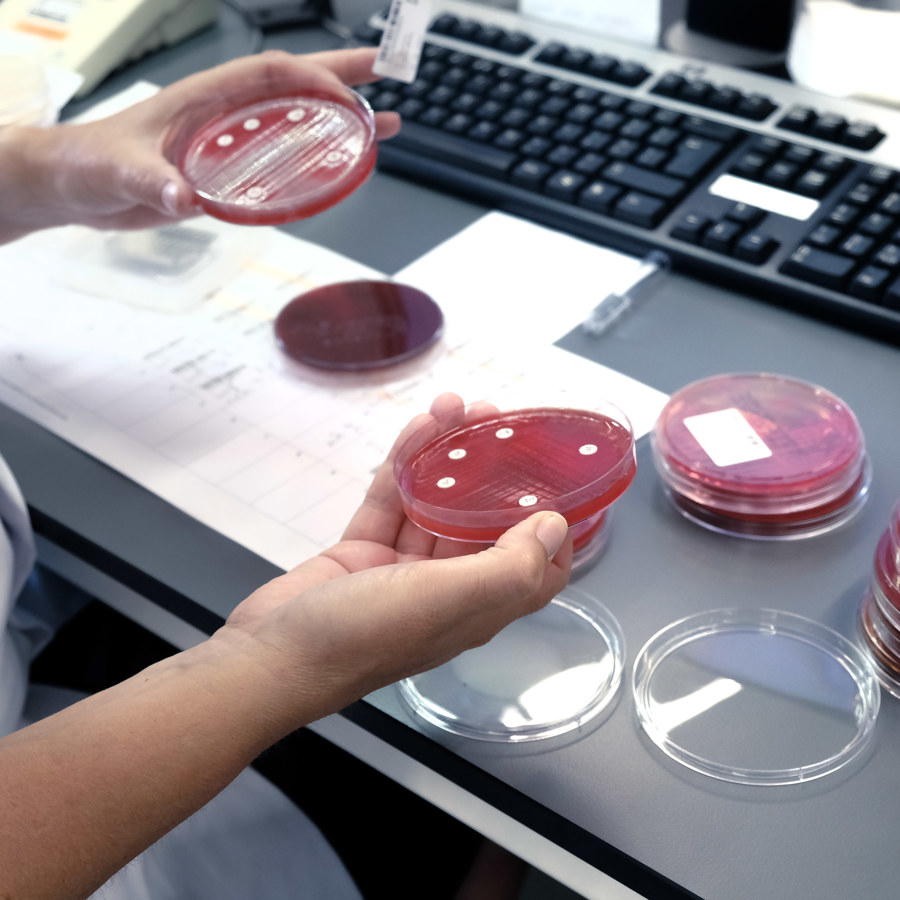

Afdeling van Medische Microbiologie
Naar welke informatie bent u op zoek?
Bekijk alle patiënteninformatie van Medische MicrobiologieOnze zorgverleners

Handig om te weten
Onderzoeken kunnen alleen aangevraagd worden door een behandelend arts. Als u materiaal moet inleveren of moet laten afnemen, zal de arts u hier altijd een aanvraagformulier voor meegeven.
Als u materiaal moet inleveren, volg dan altijd de uitleg uit de patiënteninformatie die u krijgt. Op deze manier krijgt u de meest betrouwbare uitslag.
Meestal worden onderzoeken in het ziekenhuis vergoed door uw zorgverzekeraar. Voor onderzoeken die door uw huisarts zijn aangevraagd, is het mogelijk dat het van uw eigen risico afgaat.
Soms kan het zijn dat een onderzoek niet door de verzekeraar vergoed wordt, bijvoorbeeld als u kiest om anoniem te blijven, of als u niet verzekerd bent. In dit geval is het belangrijk dat u vooraf betaalt.
Informatie met betrekking tot de laboratoriumdiensten kunt u vinden in het
Verzameldocument voor aanvragers:
Formularium Antimicrobiële middelen
Informatie huisartsen:
Normaal gesproken komt u als patiënt niet bij terecht bij de Medische Microbiologie.
Als u materiaal voor onderzoek komt brengen kunt u dit afgeven bij het Centrum voor Diagnostiek. Ook voor vragen kunt u daar terecht.
Vragen over uw uitslagen kunt u stellen aan uw behandelend arts.